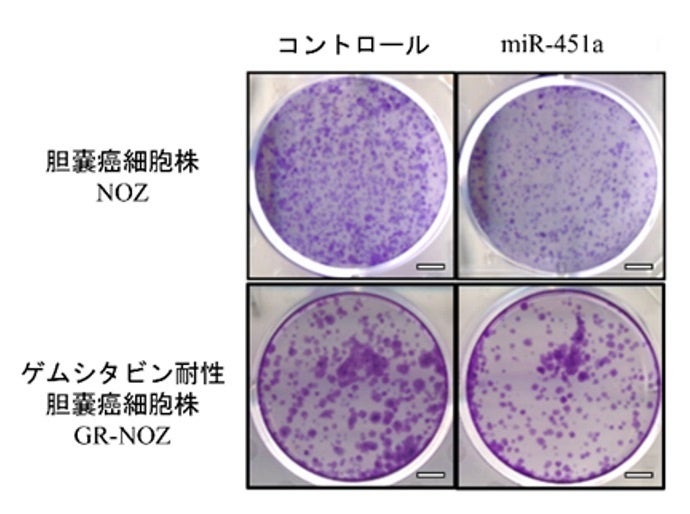
コントロールに比べて、miR-451aを導入した細胞株では細胞の集団（紫色の塊）の数が減少している

【岡山大学】難治性胆道癌に対して抗腫瘍効果を示すマイクロRNAの同定 ~ゲムシタビン抵抗性の胆道癌に対する新たな治療薬としての期待~
2023(令和5)年 11月 5日
国立大学法人岡山大学
https://www.okayama-u.ac.jp/

<発表のポイント>
進行胆道癌に対する治療において、有効な治療薬が限られていることが課題となっています。
胆道癌組織中で発現低下がみられたマイクロRNA(microRNA:mi-R)の一つであるmiR-451aを胆道癌細胞へ導入することにより細胞の増殖が抑えられることを胆嚢癌・胆管癌細胞株やスフェロイド、オルガノイドモデルを用いた実験で明らかにしました。
そのメカニズムの一端として、マクロファージ遊走阻害因子(MIF)の発現抑制とそれに続くシグナル伝達経路の制御が関与することを明らかにしました。
標準的な胆道癌治療抗癌薬「ゲムシタビン」が効かない胆道癌細胞への抗腫瘍効果も確認され、完治が難しい胆道癌に対する新規治療薬候補となることが期待されます。
◆概 要
国立大学法人岡山大学(本部:岡山市北区、学長:那須保友)岡山大学病院消化器内科の小幡泰介医員(博士課程4年)、同・堤康一郎助教、岡山大学学術研究院医歯薬学域(医)消化器・肝臓内科学の大塚基之教授らの研究グループは、miR-451aが化学療法で使用される抗癌剤ゲムシタビンに抵抗性をもつ胆道癌への抗腫瘍効果を示すことを、細胞株やより生体に近い3Dモデルを用いた実験で発見するととともに、そのメカニズムの一端を解明しました。
この研究成果は、2023年10月28日に米国遺伝子細胞治療学会の公式ジャーナルである「Molecular Therapy—Nucleic Acids」のオンライン版で公開されました。
これまでに本研究グループは、胆嚢癌組織中で発現が低下しているmiR-451aを胆嚢癌細胞へ導入することによって細胞増殖抑制を誘導されることを発表していましたが、本研究ではmiR-451aが胆嚢癌だけでなく肝内・肝外胆管癌においても細胞増殖を抑制することと、現在化学療法の第一選択薬として用いられる「ゲムシタビン」に対し耐性をもつ胆道癌にも同様の効果を認めることを発見するとともに、miR-451aによるマクロファージ遊走阻害因子(MIF)遺伝子の直接的な制御がその効果に関わっていることを明らかにしました。
本研究成果は、完治が難しい胆道癌に対する核酸医薬を用いた新たな治療戦略の確立につながることが期待されます。
コントロールに比べて、miR-451aを導入した細胞株では細胞の集団(紫色の塊)の数が減少している
コントロールに比べて、miR-451aを導入した細胞株では細胞の集団(紫色の塊)の数が減少している
 胆道癌に対するmiR-451a導入による抗腫瘍効果のメカニズム
胆道癌に対するmiR-451a導入による抗腫瘍効果のメカニズム
◆小幡泰介医員と堤康一郎助教からのひとこと
microRNAは非常に小さな分子ですが、多くの種類があり、様々な生体の反応を調整する大変興味深いRNAです。また胆道癌は、少しずつ治療の選択肢は増えてきていますが、現在でも最も治りにくい癌の一つです。今回の研究が新しい治療法につながり、胆道癌に苦しむ患者さんの助けになることを願っております。
 小幡泰介医員
小幡泰介医員
胆嚢癌患者さんの血液を用いた解析からスタートした研究が、抗癌剤抵抗性の胆道癌に対する新規治療薬としての可能性へと展開できたことは大変意義深いと思っています。臨床応用に向けてハードルもありますが、できるだけ早く患者さんに届けられるよう、さらに研究を続けていきたいと思います。
 堤康一郎助教
堤康一郎助教
◆論文情報
論 文 名:MicroRNA-451a inhibits gemcitabine-refractory biliary tract cancer progression by suppressing the MIF-mediated PI3K/AKT pathway
掲 載 紙:Molecular Therapy—Nucleic Acids
著 者:Taisuke Obata, Koichiro Tsutsumi*, Eijiro Ueta, Takashi Oda, Tatsuya Kikuchi, Soichiro Ako, Yuki Fujii, Tatsuhiro Yamazaki, Daisuke Uchida, Kazuyuki Matsumoto, Shigeru Horiguchi, Hironari Kato, Hiroyuki Okada, Motoyuki Otsuka* *:責任著者
D O I:10.1016/j.omtn.2023.102054
U R L:https://www.cell.com/molecular-therapy-family/nucleic-acids/fulltext/S2162-2531(23)00272-X
◆研究資金
本研究は、日本学術振興会(JSPS)科学研究費補助金(基盤研究C・21K07962、研究代表者:加藤博也、基盤研究C・22K08032、研究代表者:堤康一郎)およびの令和2年度岡山健康づくり財団がんに関する研究助成金の支援を受けて実施しました。
◆詳しいプレスリリースについて
難治性胆道癌に対して抗腫瘍効果を示すマイクロRNAの同定~ゲムシタビン抵抗性の胆道癌に対する新たな治療薬としての期待~
https://www.okayama-u.ac.jp/up_load_files/press_r5/press20231025-8.pdf
◆参 考
・岡山大学病院
https://www.okayama-u.ac.jp/user/hospital/
・岡山大学病院 消化器内科
https://www.okayama-u.ac.jp/user/hospital/index114.html
・岡山大学大学院医歯薬学総合研究科
https://www.mdps.okayama-u.ac.jp/


 岡山大学病院(岡山市北区)
岡山大学病院(岡山市北区)
◆本件お問い合わせ先
岡山大学病院 消化器内科 助教 堤 康一郎
〒700-8558 岡山県岡山市北区鹿田町2-5-1 岡山大学鹿田キャンパス
TEL:086-235-7219
FAX:086-225-5991
http://www.okayama-gastro.com/
<岡山大学病院との連携等に関する件(製薬・医療機器企業関係者の方)>
岡山大学病院 新医療研究開発センター
〒700-8558 岡山県岡山市北区鹿田町2-5-1
下記URLより該当する案件についてお問い合わせください
http://shin-iryo.hospital.okayama-u.ac.jp/ph_company/
<岡山大学病院との連携等に関する件(医療関係者・研究者の方)>
岡山大学病院 研究推進課 産学官連携推進担当
〒700-8558 岡山県岡山市北区鹿田町2-5-1
TEL:086-235-7983
E-mail:ouh-csnw◎adm.okayama-u.ac.jp
※ ◎を@に置き換えて下さい
http://shin-iryo.hospital.okayama-u.ac.jp/medical/
<岡山大学の産学官連携などに関するお問い合わせ先>
岡山大学研究推進機構 産学官連携本部
〒700-8530 岡山県岡山市北区津島中1-1-1 岡山大学津島キャンパス 本部棟1階
TEL:086-251-8463
E-mail:sangaku◎okayama-u.ac.jp
※ ◎を@に置き換えて下さい
https://www.orsd.okayama-u.ac.jp/
岡山大学メディア「OTD」(アプリ):https://prtimes.jp/main/html/rd/p/000000011.000072793.html
岡山大学メディア「OTD」(ウェブ):https://prtimes.jp/main/html/rd/p/000000215.000072793.html
岡山大学SDGsホームページ:https://sdgs.okayama-u.ac.jp/
岡山大学SDGs~地域社会の持続可能性を考える(YouTube):https://youtu.be/Qdqjy4mw4ik
岡山大学Image Movie (YouTube):https://youtu.be/pKMHm4XJLtw
「岡大TV」(YouTube):https://www.youtube.com/channel/UCi4hPHf_jZ1FXqJfsacUqaw
産学共創活動「岡山大学オープンイノベーションチャレンジ」2023年11月期共創活動パートナー募集中:
https://prtimes.jp/main/html/rd/p/000001761.000072793.html
岡山大学「THEインパクトランキング2021」総合ランキング 世界トップ200位以内、国内同列1位!!
https://prtimes.jp/main/html/rd/p/000000070.000072793.html
岡山大学『大学ブランド・イメージ調査2021~2022』「SDGsに積極的な大学」中国・四国1位!!
https://prtimes.jp/main/html/rd/p/000000373.000072793.html
岡山大学『企業の人事担当者から見た大学イメージ調査2022年度版』中国・四国1位!!
https://prtimes.jp/main/html/rd/p/000000122.000072793.html


国立大学法人岡山大学は、国連の「持続可能な開発目標(SDGs)」を支援しています。また、政府の第1回「ジャパンSDGsアワード」特別賞を受賞しています。地域中核・特色ある研究大学として共育共創を進める岡山大学にご期待ください
すべての画像
